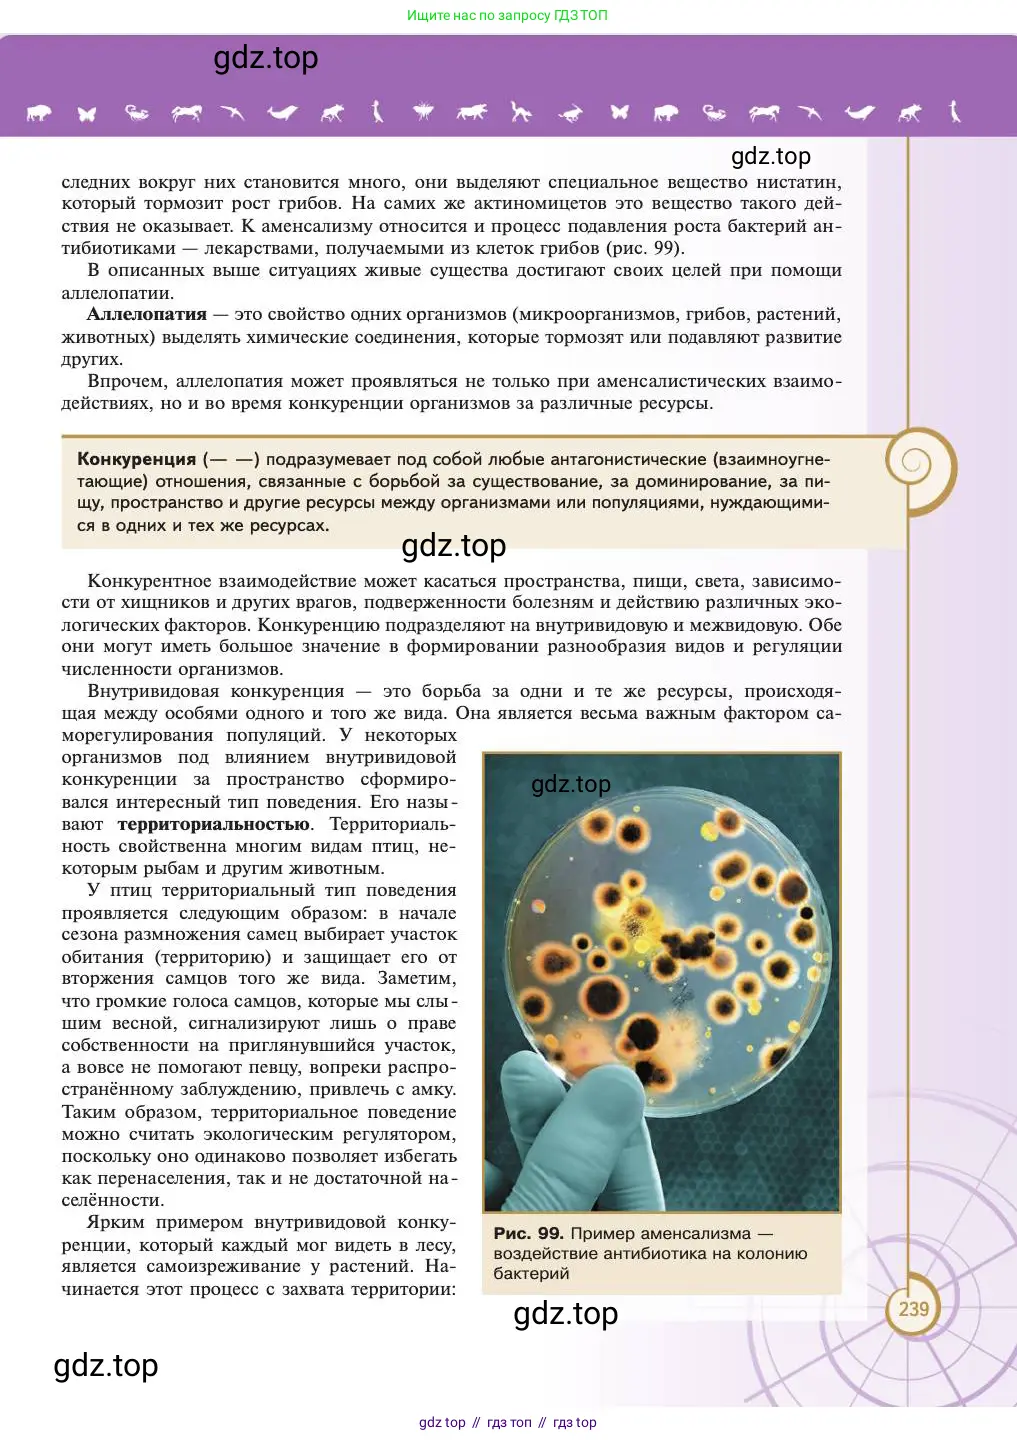
Биология, 11 класс Учебник, авторы: Пасечник Владимир Васильевич, Каменский Андрей Александрович, Рубцов Александр Михайлович, Швецов Глеб Геннадьевич, Абовян Леван Арташесович, Гапонюк Зоя Георгиевна, издательство Просвещение, Москва, 2023, страница 239

Страница 239 - гдз по биологии 11 класс учебник Пасечник, Каменский

Авторы: Пасечник В. В., Каменский А. А., Рубцов А. М., Швецов Г. Г., Абовян Л. А., Гапонюк З. Г.
Тип: Учебник
Серия: линия жизни
Издательство: Просвещение
Год издания: 2023 - 2026
Уровень обучения: углублённый
ISBN: 978-5-09-108530-3 (2023)